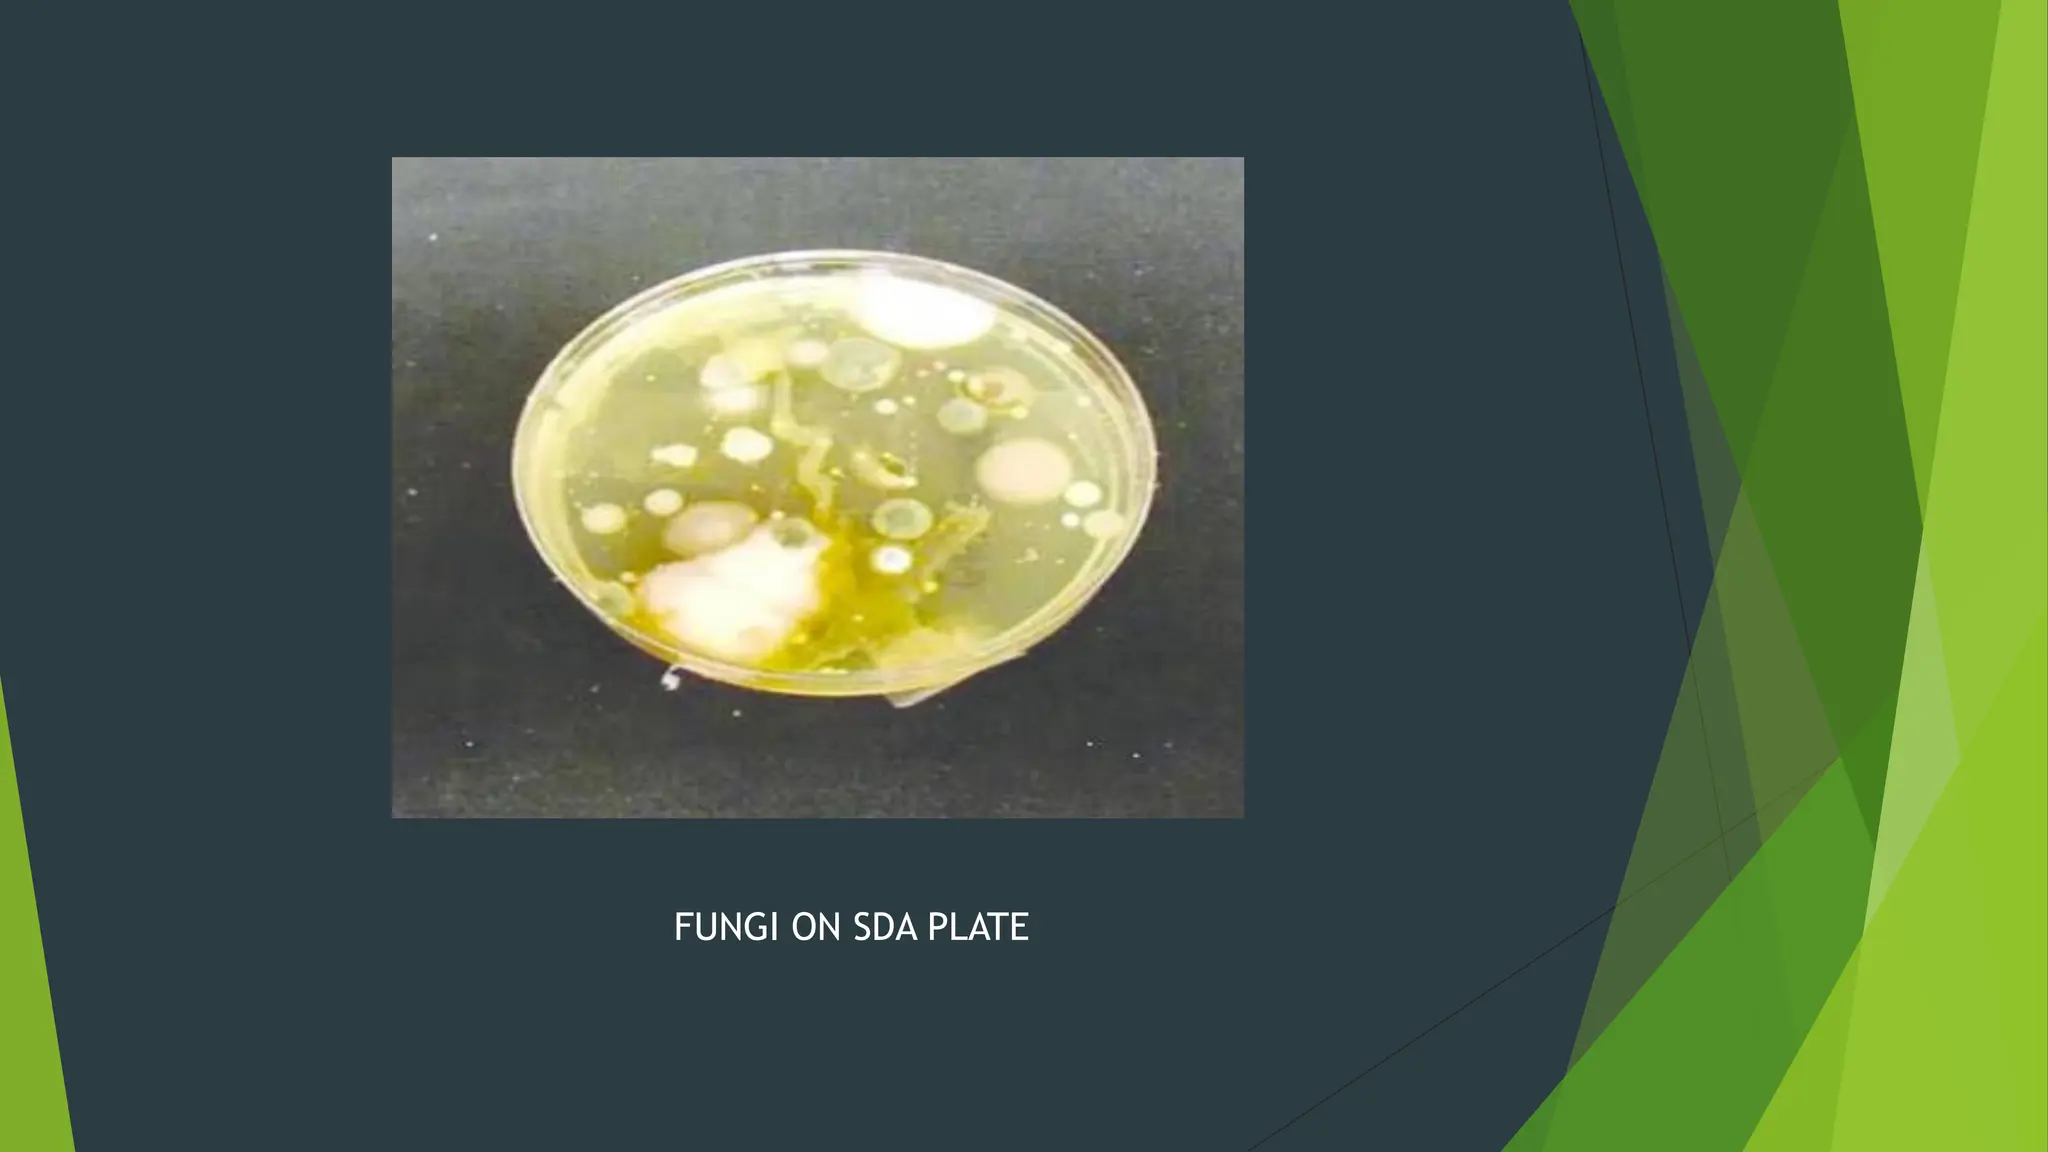
FUNGI ON SDA PLATE

The document discusses microbial contamination in herbal medicines, emphasizing sources, analytical procedures, and potential health risks due to pathogens. It outlines limits for various microorganisms, contamination analysis methods, and the importance of maintaining safety standards during production. The findings indicate that ayurvedic products from Indian markets often exhibit high levels of contamination compared to those from Italy, highlighting the need for stricter regulations and quality control in traditional medicine.